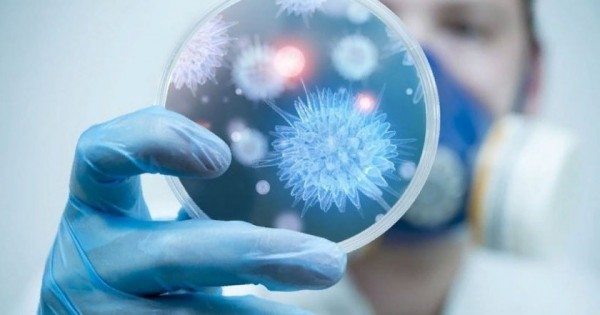

– Búginde ǵalymdardyń kúni týyp turǵandaı. Ásirese medısına ǵylymynyń qaýhary synǵa túsip jatqan sekildi. Biz ne nárseni nazardan tys qaldyrdyq?
– Bul túıtkildiń tamyry tereńde jatyr. Medısına ǵylymy ózdiginen baǵyt alyp, dańǵyl jolǵa túsip, damyp kete almaıdy. Oǵan qalaıda eldiń jalpy ǵylymǵa degen kózqarasy, saıası sheshimderi men damytý strategııalary tikeleı áser etedi. Máselen, buryn Ǵylym akademııasy ǵalymdardy ortalyqtandyryp, úlken is tyndyrdy. Keıin ony jaýyp tastady. Bul – ǵylymǵa degen nemquraıdylyqtyń anyq kórinisi. Árıne, jeń ushynan jalǵasqan jemqorlyqtyń kesiri kóp bolǵandyqtan jabylǵanyn túsinemiz. Biraq onyń ornyn basatyn eshteńe joq. Eshqandaı ǵylymı zertteý júrgizetin, ne ony basqaratyn adam joq. Nazardan tys qalǵan nárseni bilmeımin, endi kóńil bólinip jatqandaı. О́ıtkeni bizde ǵana emes, búkiálemdik qoǵam ǵylymnyń adam ómirine qanshalyqty qajet ekenin qaýip kelgende tereń túsinip jatyr
– Infeksıonıst-ǵalymdy kóp izdep, ózińizdi ázer taptyq. Bul sala shynymen zertteýsiz qalǵan ba?
– Bizdiń saladaǵy zertteý jaıyn surap otyrsyń ǵoı. «Nege álsiz?», bolmasa «Osyndaı ýaqytta nátıje nege kórinbeıdi?» degen suraq ta kókeıińde turǵan shyǵar. Sebebi bizde zerthanalar kóp bolǵanymen, bári jekeniń menshiginde ketken. Oǵan eshkim kóńil bólmeıdi. Men qazir qabyldaýyma izdep kelgen naýqastyń analızderin joldaǵan zerthana qorytyndysyna kúmánmen qaraımyn. 50 paıyz ǵana senemin, qalǵanyn óz tájirıbeme qaldyramyn. Dáriger-ǵalym juqpaly aýrýlardy zerttep, medısına ǵylymynyń naq sol salasyn damytyp, ǵylymı dáreje alaıyn dese, sheteldik jýrnaldaǵa maqala jazý kerek. Bul saladaǵy maqalalardy qabyldaı bermeıdi, sebebi bizdiń zerthanalarǵa senbeıdi. Senbegeni de durys, óıtkeni sapasy syn kótermeıdi. Aqshańyz bolsa, lısenzııa alasyz. Osydan keıin zerthana ashyńyz da jumys isteı berińiz. Zerthanalarǵa degen senim bolý úshin sapasyn anyqtaıtyn táýelsiz baqylaý qyzmeti kerek. Mundaı qyzmet tek óz mamandarymyzdan (áıtpese taǵy jemqorlyq jaılap ketedi) emes, sheteldik sarapshylardan da quralýy tıis. Ǵalymnyń zerthanalardaǵy zertteý qorytyndysy, ǵylymı jumysynyń is júzindegi nátıjesi kóńil kónshitpegen soń, sheteldik ǵylymı jýrnaldar maqalasyn baspaıdy. Odan keıin qandaı ǵylym jasalsyn?.
– Granttyq qarjylandyrý arqyly zertteý júrgizýge bolady ǵoı?
– Iá, biraq jobalardy granttyq qarjylandyrý arqyly ǵylym jasaýǵa bolady degenge óz basyp senbeımin. Bul – aılyǵy shaılyǵyna jetpeıtin ǵalymdardyń kúnkóris qamy ǵana. Ǵylym kandıdaty dárejesin alýdy toqtatty ǵoı. Osy ataqty alý úshin belgili bir taqyrypty túbine deıin zerttep, nátıjege qol jetkizesiń. Taqyrybyńdy jumys istep júrip zertteı alasyń. Al qazirgi shákirtterimnen kórip júrgenimdeı, doktorantýrada ne oqyp, ne zerttep jarytpaıdy. Aqsha tabý úshin ǵylymı zertteýine túk qatysy joq jumystarǵa jegiledi. Kandıdattyqty qaıtarýǵa bolady nemese onyń ornyn toltyratyn birdeńe bolýy kerek.
– О́zińiz S.Asfendııarov atyndaǵy Últtyq medısına ýnıversıtetinde bolashaq dáregerlerge dáris oqısyz. Jastardy ǵylymǵa tartý úshin ne isteý kerek?
– Jastardy ǵylymǵa qyzyqtyrý úshin olardyń aldyndaǵy aǵa tolqyn – bizder barlyq jaǵynan úlgi bolýymyz kerek. Mysaly, men professor, doktormyn. Al nesi bar? Mende jastar qyzyǵatyndaı qoǵamdyq bedel, balalardyń bári fýtbolıst pen ánshi bolǵysy keletinindeı joǵary jalaqy, ataǵymdy ózimnen buryn ózgeler, joǵarydaǵy men tómendegisi baǵalaıtyndaı yqpal bar ma? Joq! Búgingi tolqyndy professor, doktor, 40 jyldyq eńbek ótili bar degen dúnıelermen qyzyqtyra almaısyń. Olarǵa kóz aldynda kórinip turatyn dálel, «Men ǵylym jolyna tússem, osy professordaı adamzatqa qajet adam bolamyn!» dep umtyldyratyndaı motıvasııa kerek.
– Qazirgi koronavırýstyń aqýalyn kásibı maman retinde qalaı baǵalaısyz?
– Bul suraqty qoımasa da bolady. Qazir aqparat degen onsyz da erneýden asyp, adam mıyndaǵy qoqys shelekti toltyryp tastady ǵoı. Sondyqtan sonyń asa paıdasy joq.
– Onda mynany aıtyńyzshy. Osyndaı jaǵdaıdyń aldyn alý úshin qaıtpek kerek?
– Juqpaly aýrýlardy zertteıtin ǵalymdar qataryn árdaıym kóbeıtip otyrý kerek. Sonda qaýipti aldyn ala boljap, tym bolmaǵanda burynnan bar vırýstardy joıýdy jolǵa qoıýǵa bolady. Juqpaly aýrýlar jóninde bir nárse anyq, 1 vırýsty joısań, onyń ornyna 5-10 vırýs paıda bolady. Sondyqtan úzdiksiz damý, damytý qajet. Jalpy medısına ǵylymy damymasa, medısına damymaıtynyn túsinýge tıispiz.
Biraq bul da jetkiliksiz. О́tkendi ańsasań, bolashaqqa bet almaıtyndaı, búginmen ómir súrýden qashatyn adamdaı qabyldaıtyndar kóp. Biraq tarıh bizge sabaq alyp otyrý úshin qajet. Aıtalyq, Keńes ókimeti kezinde ýchaskelik dárigerlerdiń eń basty mindeti – saý adamdardyń densaýlyq saýattylyǵyn ashý, aýrýlardyń aldyn alý boıynsha jumys júrgizý bolatyn. «Mynaý tizimdegi juqpaly aýrýlardyń aldyn alý sharalaryn qansha adamǵa túsindirdiń?» dep esep alynatyn. Qazir qalaı? Ýchaskelik dárigerlerdiń kóbi tek qansha adamdy qabyldaǵany, jazyp bergen dárileri týraly esep berýden qoly bosamaıdy. Al óz ýchaskesindegi saý adamdardyń aýyryp qalmaýy úshin qandaı úles qosty? Ne istedi? Bul tipti umyt qalǵan.
Sodan soń salaýatty ómir saltyn saqtaýdy úıretetin pán mektepterde barlyq synypty qamtýy qajet. Voleologııa sabaǵynyń belgili bir synyptarda ǵana ótetinin qospaǵanda, ony bıologııa, medısınanyń ıisi murnyna da barmaıtyn adamdar oqytady. Oǵan qosa «halyqtyń kózi hám qulaǵy» sanalatyn medıa resýrstary da keshke deıin konsert bere bermeı, bir ýaqyt halyqtyń salaýatty salty týraly saýatyn ashýǵa úles qosýy qajet.
Bárin aıt ta birin aıt, «Birinshi baılyq – densaýlyq» degen sózdiń qadirin kesh túsinbeı, árdaıym sanaǵa sińirip turatyndaı jumys atqarylǵany abzal.
P.s. Suhbattan sońǵy «suhbat»:
– Ǵalııa Ǵabdýllaqyzy, ózekti oılaryńyz ben salmaqty suhbatyńyzǵa raqmet! Sýretińizdi qalaı alsaq bolady?
– Sýretke túsýdi múlde jaratpaımyn. Sol sýretsiz-aq shyǵara bershi, qaraǵym.



































